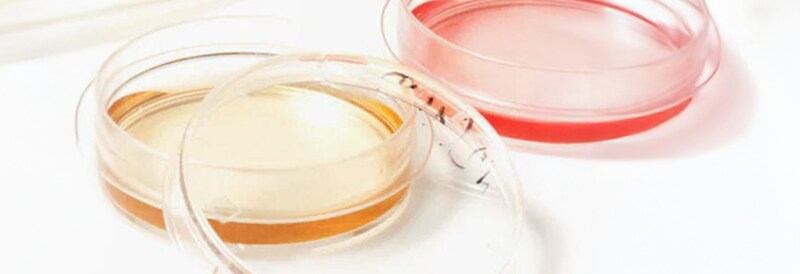
Cell Culture

Accelerate your research and product development and control costs with:
- Annual franchise and safety product growth incentives
- Consulting services to support clinical development and regulatory strategy
- Financial services, including leasing and rental options to help maximize capital budgets